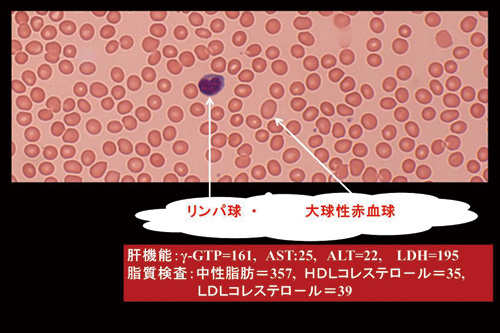

12月は師走。もう,忘年会の予約で多忙な方が多いのでは。CBC:全血算(complete blood count)を検査するだけで,長年の飲酒歴はすぐにわかります。平均赤血球容積:MCV(Mean Corpuscular Volume)の正常値は90.0です1)。今回はMCVの値から推測可能な病態を紹介します。
症例1.80歳代の男性
主訴:アルコール依存症,大球性貧血。
背景:60年間の飲酒歴,晩酌を欠かさない。
飲酒歴が長いとMCVが100以上の大球性となります。大球性の病態は肝障害,脂質異常症,ビタミンB12欠乏そして生化学的には赤血球膜脂質量の増加2)によると考えられています。この症例のビタミンB12は182pg/mLと低下していました。
| RBC:364万/μL,Ht:37.8%,Hb:12.7g/dL,MCV (mean corpuscular volume:平均赤血球容積):104.0f L,MCH(mean corpuscular hemoglobin:平均赤血球血色素値):34.8pg,PLT(血小板数):14.2万/μL |
診 断
1. 大球性貧血
2. 脂質異常症
3. アルコ-ル性肝障害
4. ビタミンB12欠乏性貧血
|
図 1 症例1の末梢血
(末梢血液画像は鹿児島市医師会臨床検査センター血液検査室へ依頼し撮影いただきました) |
症例2.40歳代後半の女性
主訴:倦怠感,たちくらみ,頭痛,寝ても寝ても眠い。
病歴:以前から健診で貧血の指摘あり。不眠のため,毎晩飲酒で入眠。
背景:毎日ビール1,000ml,喫煙歴10本/日,25年間。長男から三男まで3人の出産時にも貧血指摘あり。子宮筋腫,子宮内膜症,過多月経あり。
身長 160.8cm,体重 65.3kg,BMI 25.2。
CBC:
| RBC:423万/μL,Ht:32.3%,Hb:10.3g/dL,MCV:76.4f L,MCH:24.3pg,PLT:35.6万/μL |
診 断
1. 鉄欠乏性貧血
2. ビタミンB12欠乏性貧血
3. アルコ-ル依存症
4. 葉酸欠乏症
まとめ
赤血球指数(erythrocyte index; MCV, MCH, MCHC)は赤血球の3要素,RBC,HtおよびHbから計算で算出可能です3)。症例2ではMCV=32.3/423×1000=76.4flとなります。ところが,図2の画像では大球性,小球性低色素性赤血球の両者が混在しています。ビタミンB12欠乏による大球性と低フェリチンによる小球性低色素性という2相性の赤血球があり,平均値としてMCVが低値となったと解釈できます。
おなじ,連日飲酒という背景がありながら,MCVが104(図1)とMCVが76.4(図2)であった2症例を紹介いたしました。
 |
図 1 症例2の末梢血:大小不同1+あり,多染性1+
(末梢血液画像は鹿児島市医師会臨床検査センター血液検査室へ依頼し撮影いただきました) |
文 献
1.後藤明彦:末梢血検査と貧血の鑑別 最新医学別冊号 125:66-73.2017
2.Takemoto Y: Use of Iatroscan for the analysis of red cell membrane lipids. Kawasaki Med J 6: 1-18.1980
3.柴田 進:図解血液病学 金芳堂 1988年12月 初版

|